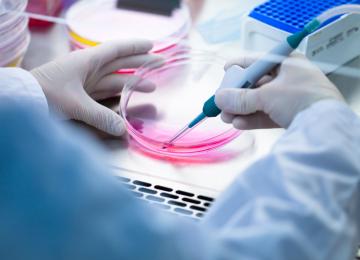

Although it is globally recognized that early detection is effective in successful treatment of breast cancer, yet 35% of Iranian women afflicted with the disease are diagnosed late, compared to…
People
Nursing has become one of the five most wanted majors in the country, said Ali Dadgari, director of the Health Ministry’s nursing department for empowerment, promotion, and incorporation of human…
The first comprehensive laboratory for blood type and genotype has been inaugurated at the Iran Blood Transfusion Organization.
The lab is said to be the only one of its kind in the Middle…
The head of the Food and Drug Administration said on Monday that no genetically modified product is made in the country.
“Only genetically modified soy and corn oil products have import…
Over 21% of the student population in the country is obese, said Mehrzad Hamidi, physical education and health deputy at the Health Ministry. “If current trends continue, we will face a tsunami of…
Six southern provinces namely Sistan- Baluchestan, Kerman, Hormozgan, Fars, Bushehr and Khuzestan, will again see heavy rainfall from Wednesday, says the Iran Meteorological Organization (IMO).
A large portion of the United Nations’ budget for combating dust storms and desertification is allocated to Africa while Middle Eastern countries, which are also struggling with drought and dust…
The US state of California’s decision to extend drought restrictions despite rain and snow has met with splash back from some waterlogged residents.
The State Water Resources Control Board…
China’s Ministry of Environmental Protection on Sunday named and shamed several cities in north China for not doing enough to cope with air pollution.
Energy Minister Hamid Chitchian said recent flooding in the southern regions of Fars Province has helped replenish reservoirs and slightly alleviate drought conditions.
“Due to the large…
The US Senate Environment and Public Works Committee held hearings on Wednesday to discuss legislation that would weaken the Endangered Species Act.
A mother singing to her baby is such a normal event that most people give the subject little thought. But why do mothers do it, and what can we learn from it?
Singing to babies is…
Nearly 33,227 people with HIV/AIDS have been identified in the country, of whom 84% are men and 16% women, as per the official figures released last October.
Over the past couple of years, Iran has been pressing ahead with its program to boost vaccine production and reach self-sufficiency in several types of the life-saving antigenic substance.
There are 18 temporary safe shelters in 18 provinces of the country to house and support victims of domestic violence and abuse, and runaway girls. “The last shelter was opened in North Khorasan…
Over 2,100 homeless people have been provided warm shelters since Saturday in Tehran, after the temperature dropped several degrees and a white blanket of snow covered most of the city’s…
About 20%-70% of addiction vulnerability is genetic, said Hamidreza Khorram-Khorshid, president of Tehran’s University of Social Welfare and Rehabilitation Sciences. “Many genes influence…
A meeting between head of Passive Defense Organization of Iran Colonel Gholamreza Jalali and head of Food and Drug Administration Dr. Rasoul Dinarvand was recently held to devise ways to develop…
The 2nd International conference on regenerative medicine will be held July 12-14 at Iran International Conference Center in Tehran. So far, 15 international scientists and 25 expatriate Iranian…
The biggest national project to treat patients with Cerebral Palsy (CP) through injection of stems cells from umbilical cord blood into the brain will be trialed in the country by the end of the…
If your marriage is going through a tricky patch you are better off sticking it out, new research suggests.
A study from the UK’s Marriage Foundation has found that couples who stayed…
Rescue and relief teams from the Iranian Red Crescent Society (IRCS) have been dispatched to Fars, Bushehr and other provinces following inclement weather in the past few days in various parts of…
Iranian specialists discussed the latest technology in the treatment of artery stenosis at the fourth national atherothrombosis conference in Tehran on Friday, on the occasion of the International…
An outbreak of H7N9 bird flu in China killed 79 people in January, the country’s national health authority said. More than 250 cases of H7N9 have been reported to the National Health and Family…
Fifty student associations on brain and cognitive sciences will open simultaneously across Iranian universities on the occasion of the National Brain Awareness Week. Organized by the Iranian…